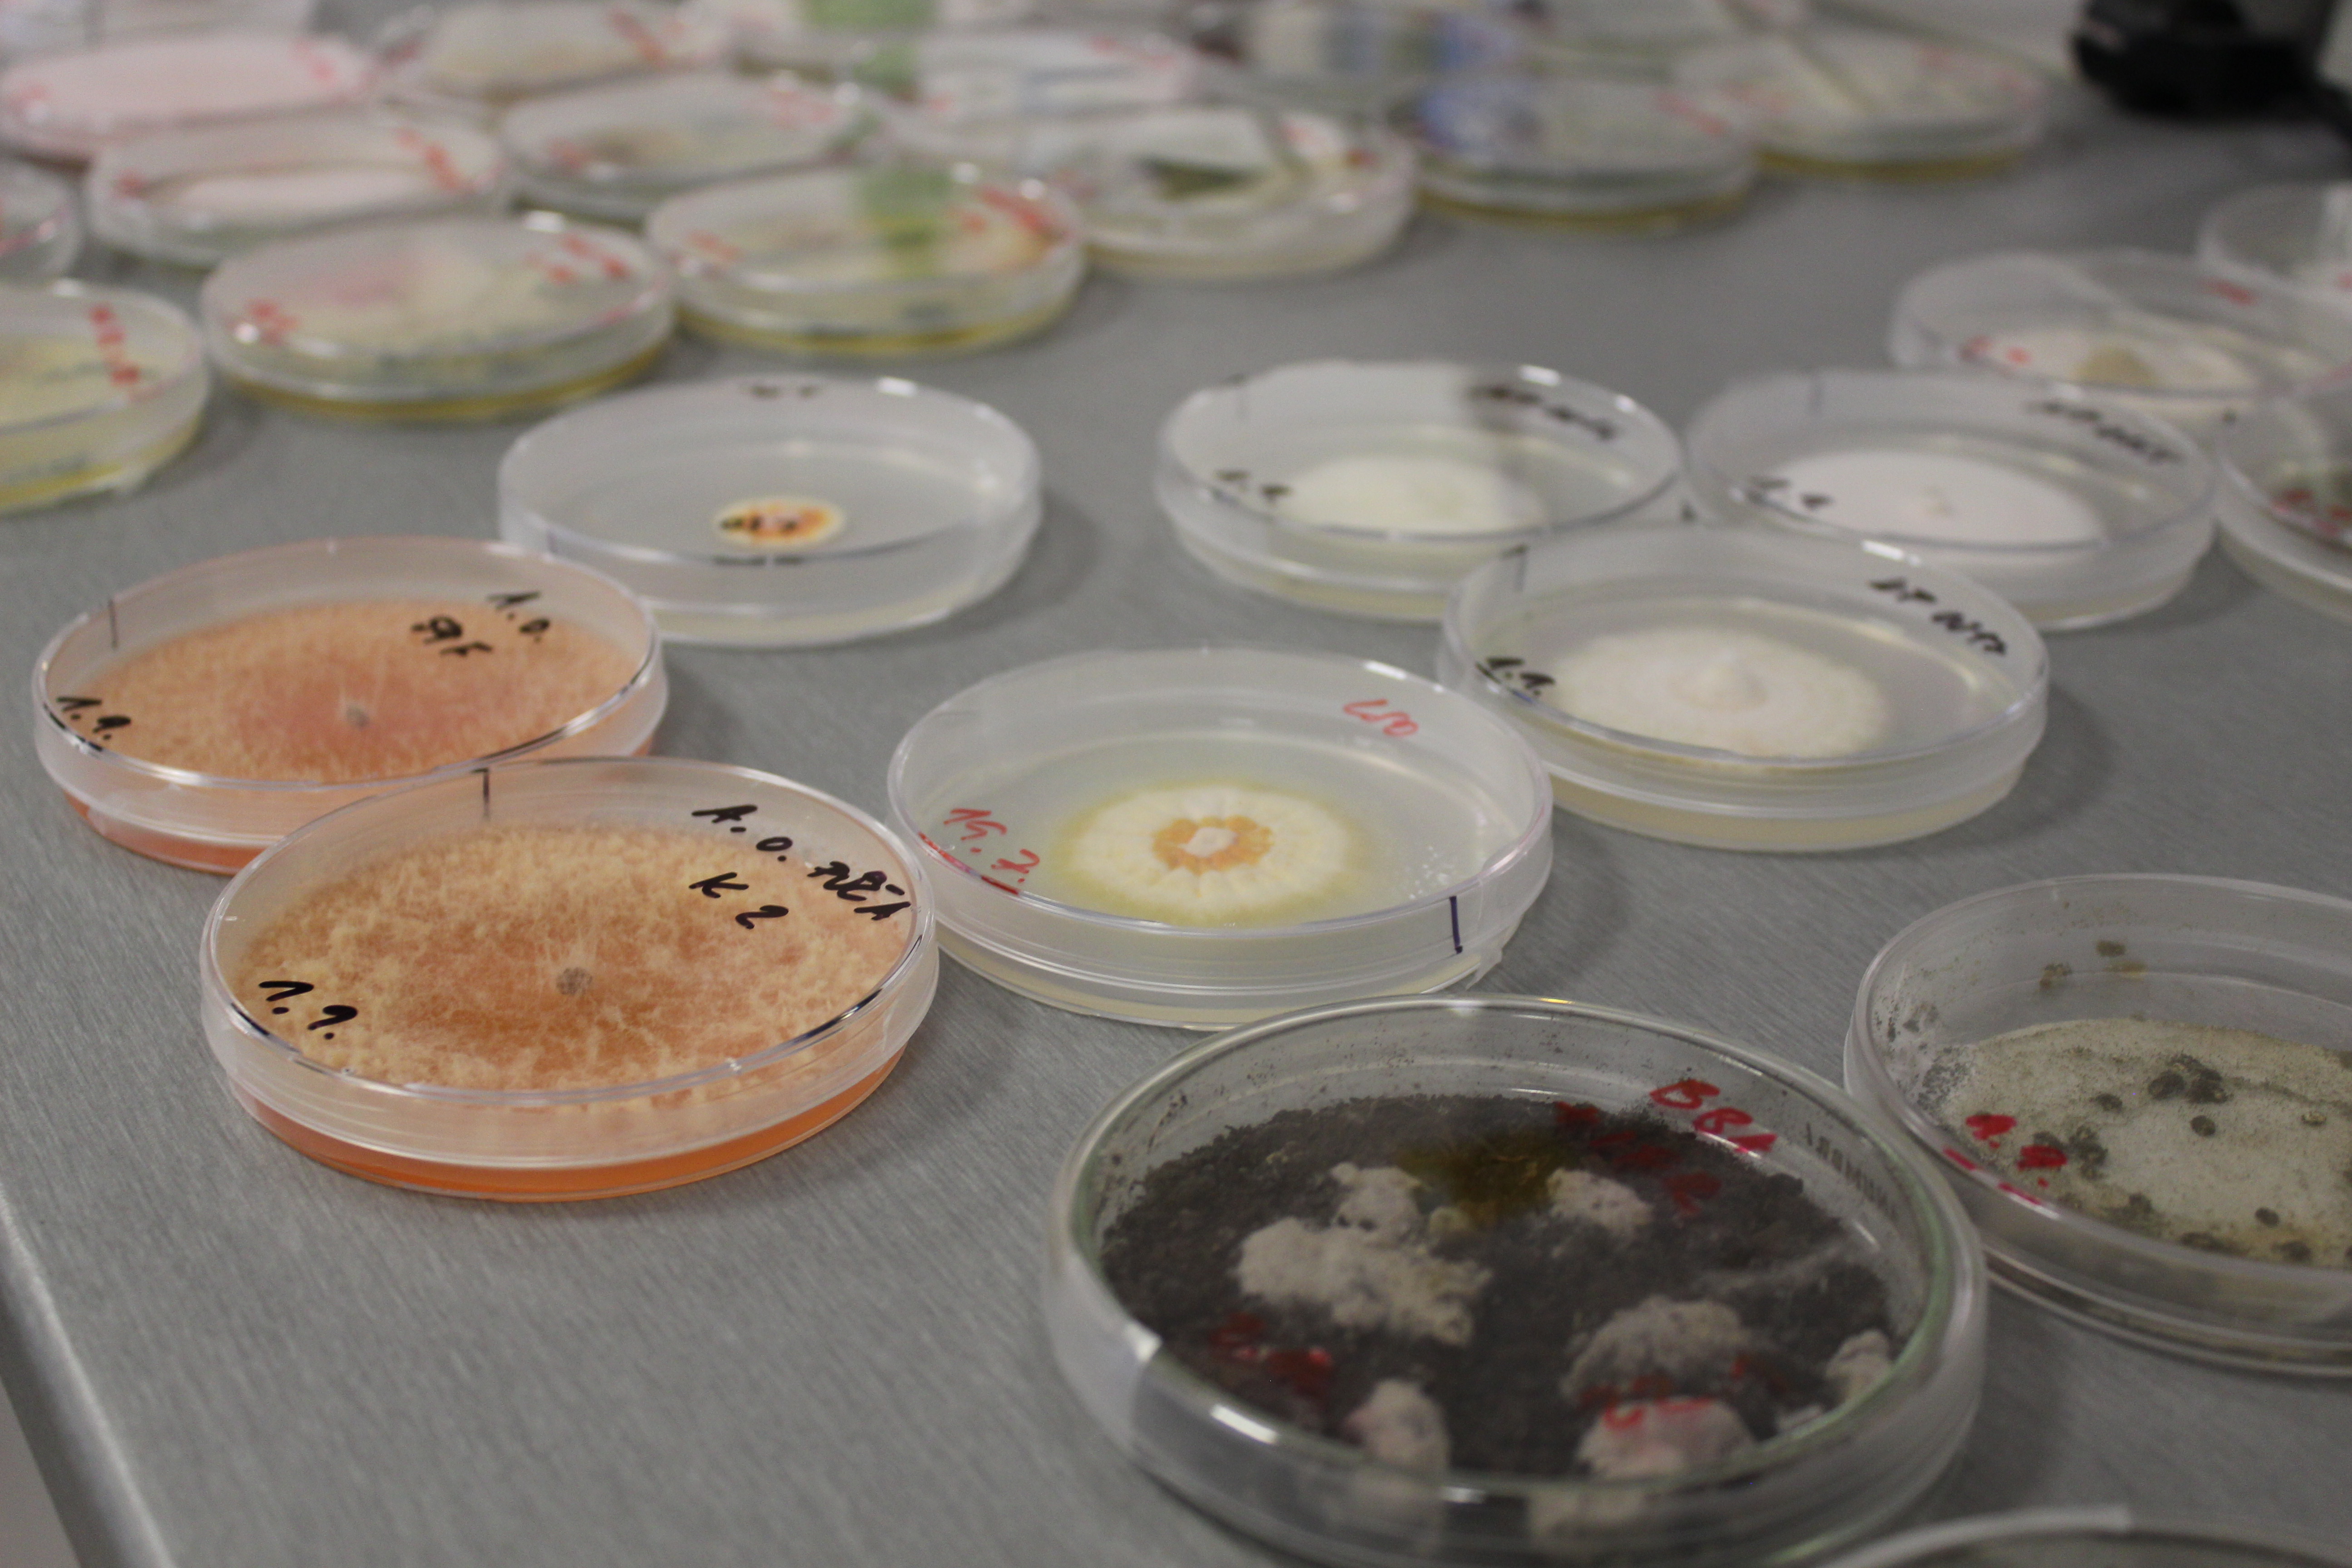

Fakulta
Uchazeči
Studium
Věda a výzkum
Mezinárodní spolupráce
Kontakty
Studium
Mezinárodní spolupráce
I budovy Zemědělské fakulty Jihočeské univerzity ožily v pátek 24. 9. 2021 v rámci Noci vědců. Tématem letošního ročníku byl ČAS. Noc vědců 2021 už je minulostí, jaká byla?
V Muzeu pivovarnictví se mohli návštěvníci seznámit s historií vaření piva na našem území nebo s postupem výroby piva ve virtuální realitě.
S Katedrou zemědělské, dopravní a manipulační techniky bylo možné proniknout do tajů 3D tisku a využití umělé inteligence v zemědělství.

Na Katedře rostlinné výroby jste mohli poznat polní plodiny pěstované u nás a některé i ochutnat. Dozvědět se o praktickém využití užitečných druhů hub v biologické ochraně rostlin proti škůdcům a v laboratoři nahlédnout do vývoje hmyzu v čase.
Zajímavosti o šlechtění v běhu času – od Mendela do postgenomické éry: jak molekulární biologie ušetří čas ve šlechtění rostlin, si pro návštěvníky připravila Katedra genetiky a zemědělských biotechnologií.

Různé fermentační mikroorganismy si bylo možné prohlédnout pod mikroskopem na Katedře potravinářských biotechnologií a kvality zemědělských produktů. Zde bylo také možné ochutnat čerstvou zmrzlinu, jogurty a sýry vyrobené přímo pro Noc vědců.

Katedra agroekosystémů si pro posluchače připravila v atriu povídání na téma: Každá rostlina potřebuje svůj čas: Indoorové pěstitelské systémy a zelené stěny.

Moc děkujeme všem, kteří se do akce zapojili, a samozřejmě Vám všem návštěvníkům, kteří navštívili náš program!